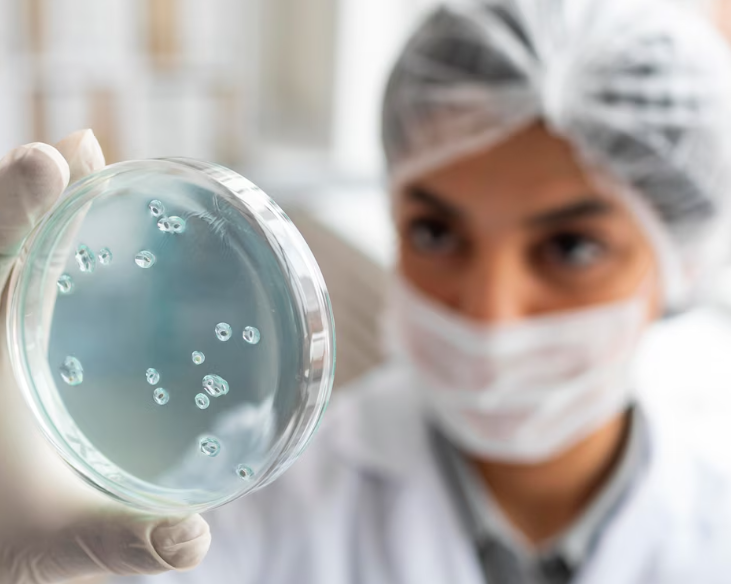

Учёные совершили прорыв в создании яйцеклеток из клеток кожи
Учёные из Орегонского университета здоровья и науки сделали важное открытие. Они научились превращать клетки кожи в яйцеклетки, которые могут создавать ранние человеческие эмбрионы. Это исследование было опубликовано в научном журнале под названием Nature Communications.
Эта новая технология может помочь женщинам, которые не могут иметь детей по разным причинам, например, из-за возраста или болезней. Она также может дать шанс однополым парам стать родителями, если один из партнёров сможет предоставить свою яйцеклетку.
Однако учёные предупреждают, что этот метод ещё не готов для широкого использования. Им нужно провести ещё много исследований, чтобы убедиться, что он безопасен и эффективен. По их оценкам, это может занять около десяти лет.
Тем не менее, это большое достижение. Учёные назвали свой метод «митомейозом», что означает сочетание двух способов деления клеток, которые обычно происходят в природе. Обычно клетки делятся на две идентичные копии (это называется митоз), а клетки, из которых получаются сперматозоиды и яйцеклетки, делятся по-другому, чтобы в итоге получилось правильное количество хромосом для оплодотворения (это называется мейоз).
© 2015-2025 Сетевое издание «Фактом». Зарегистрировано в Федеральной службе по надзору в сфере связи, информационных технологий и массовых коммуникаций (Роскомнадзор).
Реестровая запись ЭЛ No ФС 77 - 67652 от 10.11.2016.